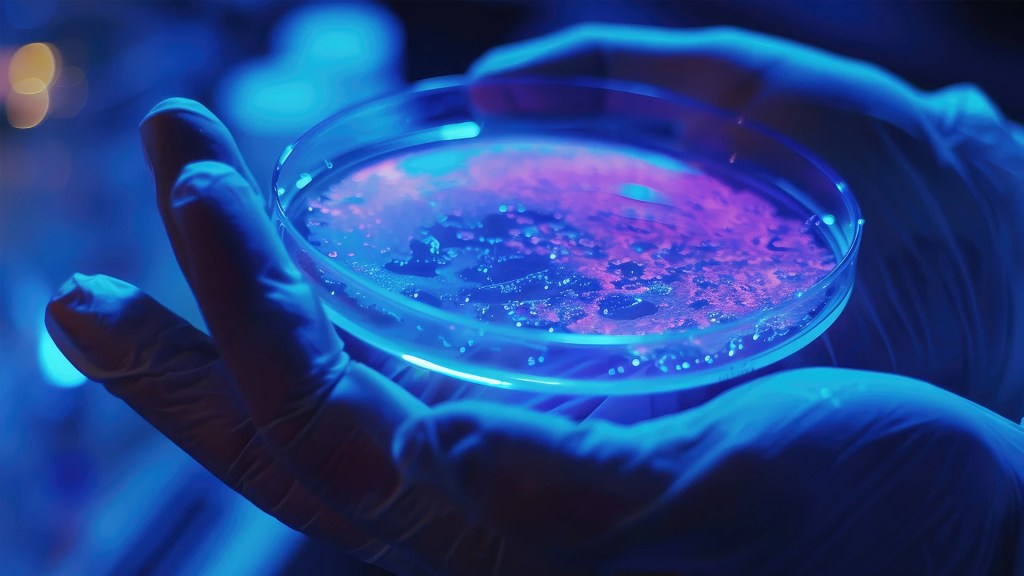
petri dish in hands

Capabilities
Integrating Capabilities That Define the Future of Defense
From tactical UAS and loitering munitions to counter-UAS and AI-enabled autonomy, AV delivers scalable solutions that help forces detect, decide, and act faster in contested environments—extending reach, enhancing survivability, and reducing risk.
Capabilities
-
Defense & Precision Strike 
Defense & Precision Strike
Learn More -
Intelligence, Surveillance and Reconnaissance 
Intelligence, Surveillance and Reconnaissance
Learn More -
Unmanned Systems 
Unmanned Systems
Learn More -
Counter-UAS 
Counter-UAS
Learn More -
Directed Energy 
Directed Energy
Learn More -
Electronic Warfare 
Electronic Warfare
Learn More -
AI, Autonomy & Decision Support 
AI, Autonomy & Decision Support
Learn More -
Space Systems & Resilient Communications 
Space Systems & Resilient Communications
Learn More -
Force Protection & Base Defense 
Force Protection & Base Defense
Learn More -
Training & Support Services 
Training & Support Services
Learn More -
AV_Halo Software 
AV_Halo Software
Learn More -
Ground Control Solutions 
Ground Control Solutions
Learn More -
Emerging Technologies
Emerging Technologies
Learn More
Our Domains
Delivering Advantage Across Every Domain
Air
AV leads in ISR, loitering munitions, and C-UAS systems enabling rapid, mission-critical threat response.
Land
AV’s rugged, all-terrain UGVs deliver precision manipulation, autonomous operation, and maximum mission flexibility.
Sea
AV provides naval forces with multi-domain awareness through advanced UAS and undersea systems operating above and below the surface.
Space
AV delivers mission-proven solutions for space domain awareness, resilient communications, and command and control.
Cyber
AV develops advanced cyber capabilities across offensive and defensive operations to secure advantage in the digital battlespace.